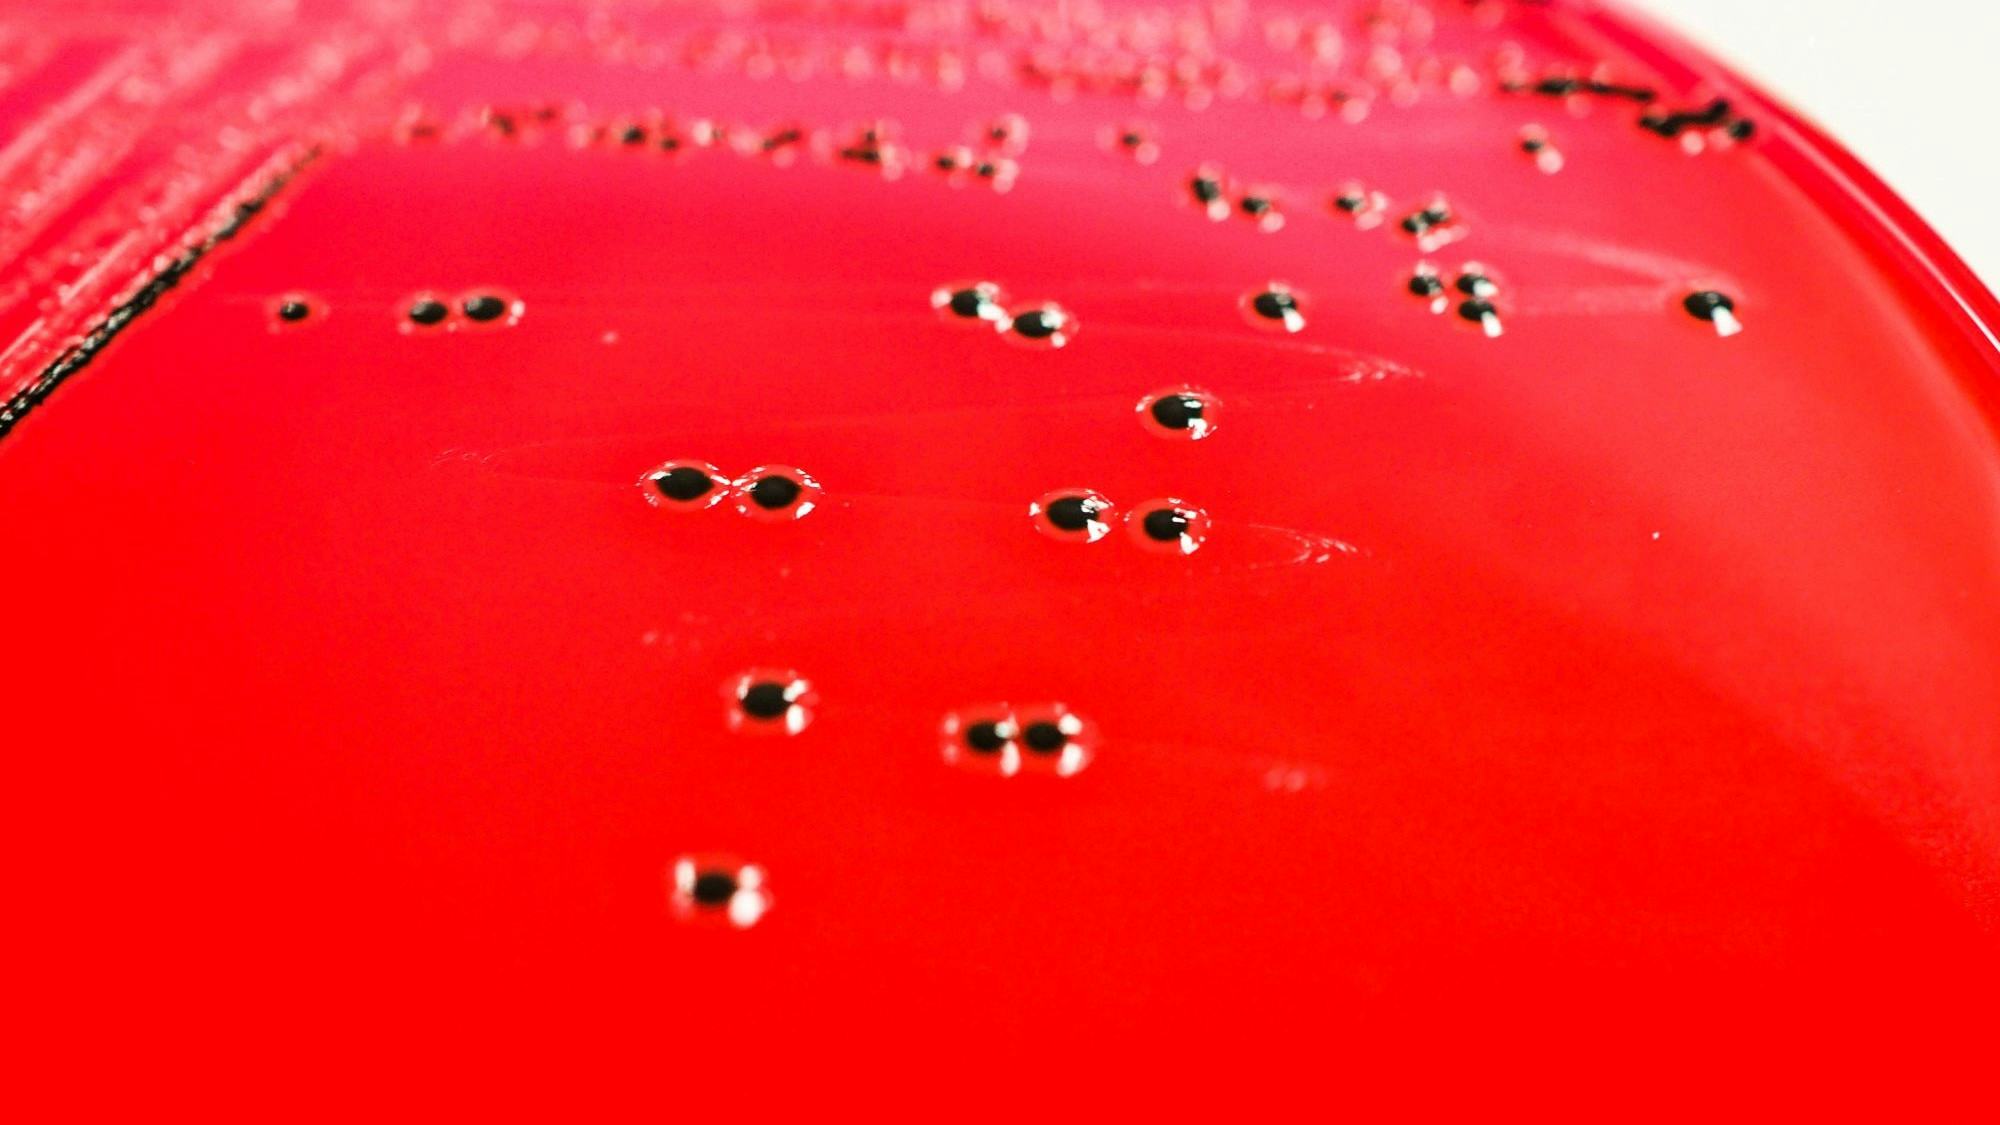
Afbeelding: Shutterstock

Voor abonnees 84 zieken in Verenigd Koninkrijk door salmonella in gefermenteerde droge worst
In het Verenigd Koninkrijk zijn 84 mensen ziek geworden door een uitbraak van salmonella. Onderzoek wijst op de gefermenteerde droge worst Bastides Saucisson Sec als waarschijnlijke bron. Meer dan een derde van de patiënten werd opgenomen in het ziekenhuis. Het product is inmiddels teruggeroepen.